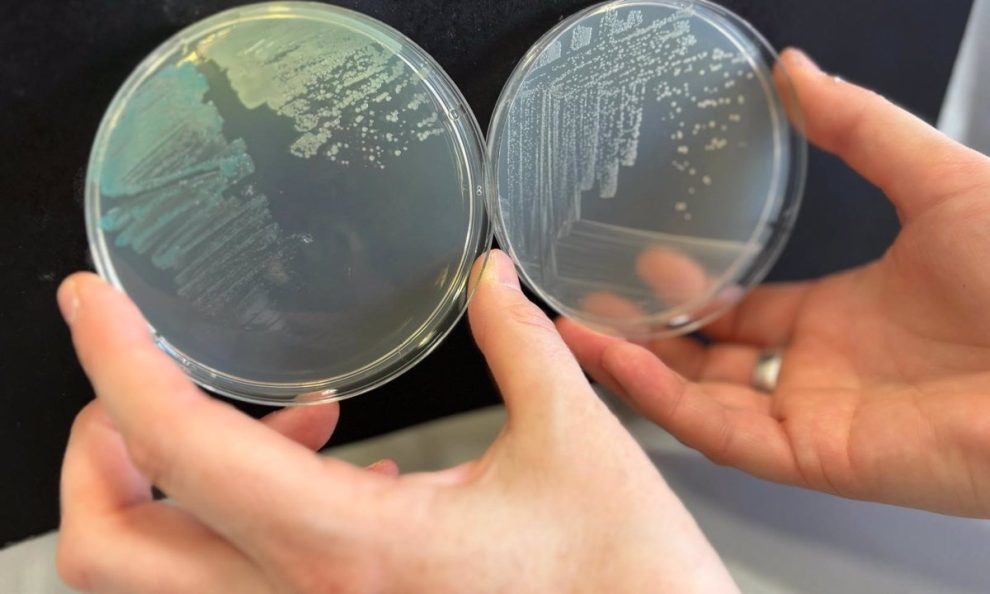
8227541581.png

MADRID, 16 de julio (EUROPA PRESS) –
Un descubrimiento inesperado ha supuesto importantes avances en la lucha contra las bacterias dañinas. Un equipo internacional de investigadores, dirigido por el profesor Peter Fineran de la Universidad de Otago, Nueva Zelanda, estudió un tipo particular de proteína utilizada por los virus para infectar bacterias, llamada bacteriófago
La carrera armamentista microscópica entre. bacterias y bacteriófagos es importante porque podría conducir a alternativas a los antibióticos. Publicado en la revista Nature, el estudio analizó una proteína utilizada por los fagos cuando implementan anti-CRISPR, un método para bloquear el sistema inmunológico CRISPR-Cas de las bacterias
Autor principal Nils Birkholz, del Departamento. Microbiología e Inmunología de Otago dice que comprender cómo interactúan los fagos con las bacterias es un paso importante en el camino hacia el uso de fagos contra patógenos bacterianos en la salud humana o la agricultura. “Específicamente, necesitamos conocer los mecanismos de defensa, como CRISPR, que usan las bacterias para protegerse contra la infección por fagos, de la misma manera que usamos el sistema inmunológico del cuerpo para combatir los virus y cómo los fagos pueden contrarrestar estos mecanismos de defensa”.
“Por ejemplo, si sabemos cómo los fagos matan un tipo particular de bacteria, esto nos ayudará a identificar fagos adecuados para su uso como antimicrobianos. En particular, es importante comprender cómo los fagos controlan su arsenal de defensa, incluido el anti-CRISPR, después de una infección: necesitamos comprender cómo los fagos regulan la expresión de genes que son útiles en su lucha contra las bacterias”, dijo.
El estudio también reveló cuán cuidadosos son los fagos cuando usan su anti-CRISPR. “Ya sabemos que una proteína de un fago en particular tiene una parte o dominio que es muy común en muchas proteínas involucradas en la regulación genética; Este dominio hélice-giro-hélice (HTH) puede unirse específicamente a secuencias de ADN y, según el contexto, activar o desactivar un gen. “Lo que descubrimos es que el dominio HTH de esta proteína es mucho más flexible y presenta una característica previamente desconocida. método de ajuste. Puede utilizar este dominio no sólo para unirse al ADN sino también a su transcripción de ARN, la molécula que actúa como intermediaria entre la secuencia de ADN y el agente anti-CRISPR codificado allí. Dado que esta proteína participa en la regulación de la producción anti-CRISPR, esto significa que esta regulación tiene capas adicionales: no ocurre únicamente a través del mecanismo. Se une al ADN, pero también gracias al nuevo mecanismo que hemos descubierto se une al ARN mensajero”, explica el experto.
Los investigadores afirman que este descubrimiento puede tener una gran importancia para comprender la regulación genética. “Decodificar esta regulación sorprendentemente compleja representa un paso importante hacia la comprensión de cómo los fagos pueden evadir el sistema de defensa CRISPR-Cas y matar las bacterias objetivo en una variedad de usos. Este descubrimiento es de particular interés para la comunidad científica porque revela un nuevo mecanismo regulador en una familia de bacterias. “Los dominios HTH han sido objeto de extensas investigaciones desde su descubrimiento a principios de los años 1980. Por lo tanto, inicialmente se pensó que esta proteína funcionaría como cualquier otra proteína que posea un dominio HTH. “Nos sorprendió descubrir este nuevo método de operación. Este hallazgo tiene el potencial de cambiar la forma en que el campo ve la función y el mecanismo de este importante y extendido dominio proteico, y podría tener implicaciones importantes para nuestra comprensión de la regulación”, concluyó.